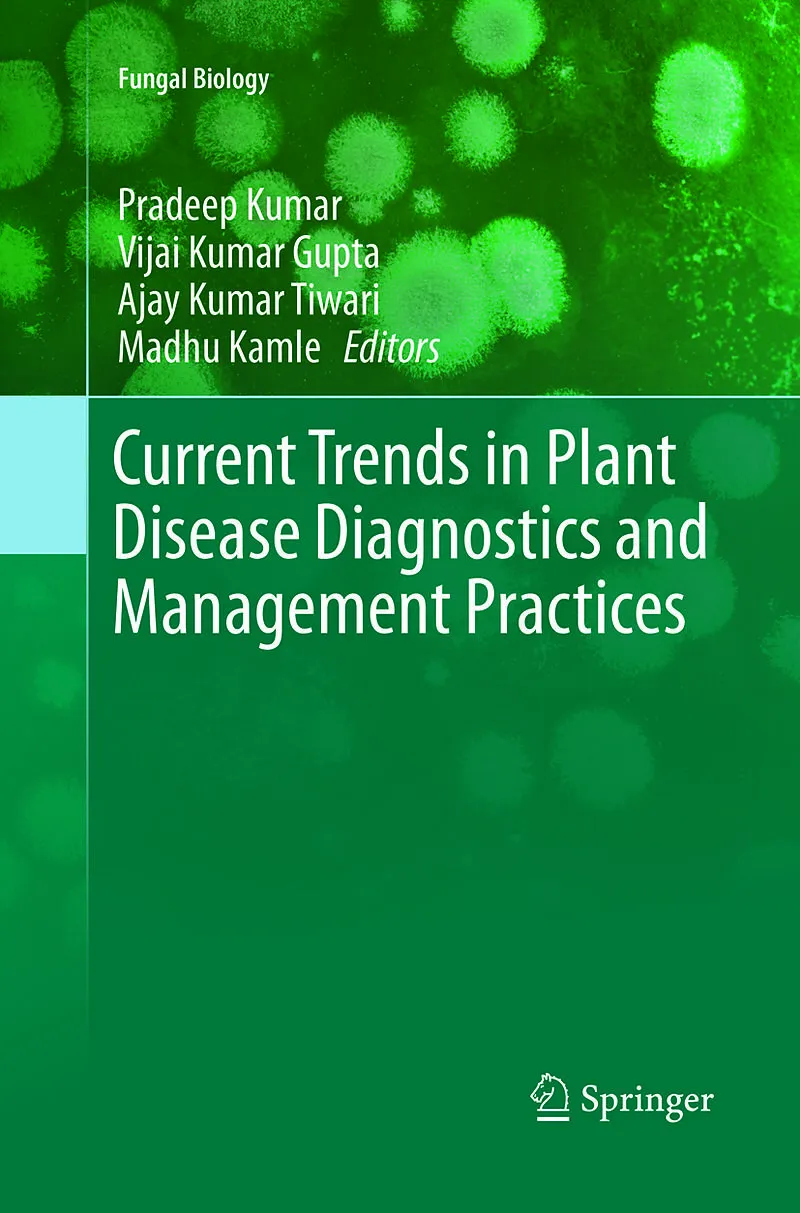

Willkommen. Schön, sind Sie da!
0

Current Trends in Plant Disease Diagnostics and Management Practices
Rabatt
Beschreibung
Plant diseases play an important role on our daily lives. Most of plant diseases are visible and are caused by biotic and/or abiotic factors. Symptoms are usually the results of a morphological change, alteration or damage to plant tissue and/or cells due to a...Format auswählen
- Kartonierter EinbandCHF 223.90
- Fester EinbandCHF 223.90
- E-Book (pdf)CHF 236.90
-10%Sie sparen CHF 24.90
CHF223.90
Print on Demand - Exemplar wird für Sie besorgt.
Kostenlose Lieferung
